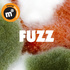

Eigentlich kommen die vier Herren aus ganz verschiedenen Regionen der Musikszene, auch ihre Vorbilder driften dabei in alle möglichen Richtungen, was die gemeinsame Arbeit an ihrem schier unerschöpflichen Fundus an neuen Songideen so extrem spannend macht.
Denn beim Songwriting orientieren sie sich dann gemeinsam an all diesen zahlreichen musikalischen Phasen, die ihre Kindheit und Jugend maßgeblich geprägt haben, um so ihre bestehenden Träume und Wünsche in die Blaupause des vorliegenden Songs einzuarbeiten.
Träume und Wünsche – genau, das ist auch der Motor, der sie immer wieder zu neuen Abenteuern mit dieser ganz eigenen Vierer-Beziehung antreibt. Und es ist in der Tat eine Beziehung – intensiv, grundehrlich und verlässlich mit allen Höhen, Tiefen, Krisen und Erfolgen.
Wohin die Reise geht, weiß eigentlich keiner von ihnen, nur dass sie sehr gerne noch eine ganze Weile unterwegs sein möchten, es gibt doch noch so viel zu entdecken – und vor allem gibt es noch so viele mehr von euch da draußen, welche unbedingt die Bekanntschaft mit dieser Indie-Rock-Band mit dem wohlklingenden Namen „mental reservation“ machen sollten…
Denn beim Songwriting orientieren sie sich dann gemeinsam an all diesen zahlreichen musikalischen Phasen, die ihre Kindheit und Jugend maßgeblich geprägt haben, um so ihre bestehenden Träume und Wünsche in die Blaupause des vorliegenden Songs einzuarbeiten.
Träume und Wünsche – genau, das ist auch der Motor, der sie immer wieder zu neuen Abenteuern mit dieser ganz eigenen Vierer-Beziehung antreibt. Und es ist in der Tat eine Beziehung – intensiv, grundehrlich und verlässlich mit allen Höhen, Tiefen, Krisen und Erfolgen.
Wohin die Reise geht, weiß eigentlich keiner von ihnen, nur dass sie sehr gerne noch eine ganze Weile unterwegs sein möchten, es gibt doch noch so viel zu entdecken – und vor allem gibt es noch so viele mehr von euch da draußen, welche unbedingt die Bekanntschaft mit dieser Indie-Rock-Band mit dem wohlklingenden Namen „mental reservation“ machen sollten…
Album: BERLIN
BERLIN
David Bowie hat es getan! U2 haben es getan!Und nun auch MR - die intensive Arbeit, die außergewöhnlichen Erlebnisse und prägenden Erfahrungen in Berlin bekommen nun mit dem Erscheinen des neuen Albums ein wohl verdientes Denkmal gesetzt, auf welches man einfach nur stolz sein kann.
Wir wollen es nicht übertreiben, aber dieses Werk gehört einfach in die Nominierungsliste der „besten Alben 2018“.
Man könnte jetzt Größenwahn oder Realitätsverlust vermuten oder sich einfach selbst überzeugen…
Danach wird alles anders sein!
Album: FUZZ
FUZZ
Mental Reservation schlagen mit ihrem kommenden Album in jeglicher Hinsicht ein neues Kapitel auf. Nicht nur der Sound der Band aus Darmstadt hat sich verändert, sondern auch der rote Faden des Albums dreht sich um das Thema Veränderung und Selbstfindung. Die Songs klingen frisch und ausgefeilt und gehen direkt ins Ohr. Dabei wird deutlich, dass die Band einen weiteren großen Schritt nach vorne genommen hat. Nun wollen die vier Musiker ihre Zuhörer weltweit überzeugen.Zur klassischen Rockbesetzung mit zwei Gitarren, Bass und Drums gesellen sich vermehrt Cello sowie mal eine Mandoline, aber auch einige Gastmusiker sind zu hören. Aufgrund ihrer handgemachten Pop-Rock-Songs mit britischem Einschlag werden sie gerne als die deutsche Antwort auf den Post-Brit-Pop bezeichnet. Parallelen zu Travis, Oasis, Keane und Coldplay sind nicht zu leugnen.
Album: yesterday's snow
yesterday's snow
Das lange erwartete neue Album der vier Jungs!Ein ergreifender Trip durch eine Welt voller akustischer Emotionen - Wut, Trauer, Verzweiflung reihen sich an erfrischende Euphorie begleitet von süßer Melancholie...
Album: What Did You Expect ?
What Did You Expect ?
Der Erstling - Acoustic Alternative Rock vom Allerfeinsten für die besonderen Momente ...Album: Made in DA Vol.I
Made in DA Vol.I
Der Darmstädter Sampler aus dem Jahre 2010 gesammelt und aufgenommen in den "theLAB"-Studios von Danny Irmscher, auf welchem u.a. unser exklusiver Beitrag "Cold" zu finden ist...
20350 mal aufgerufen
340:36:00 Stunden angehört
63203 mal angehört